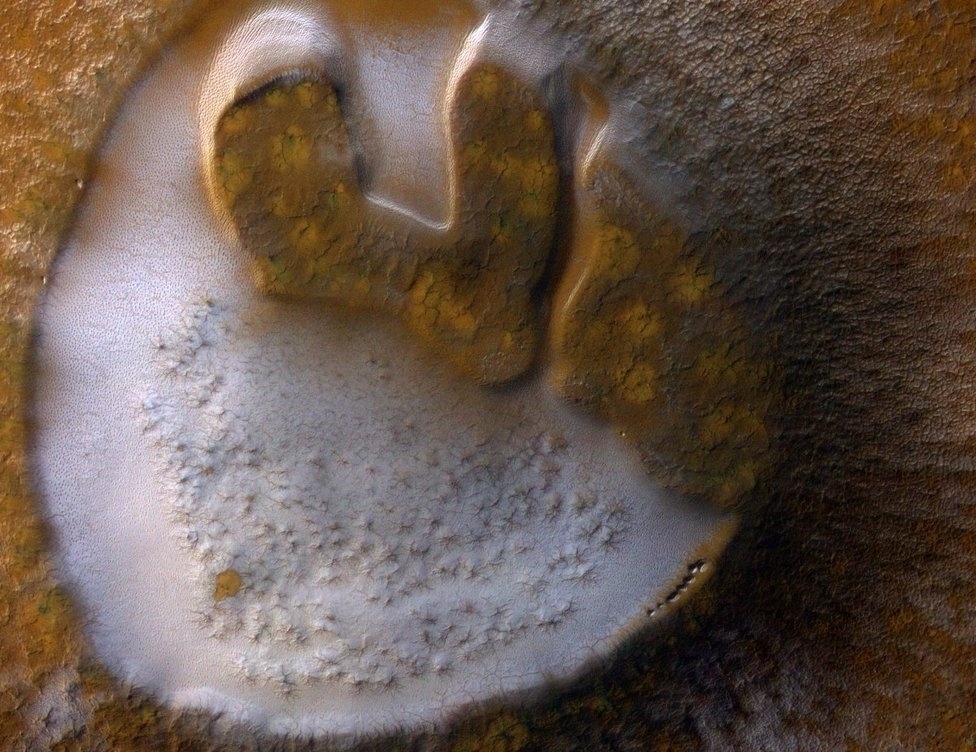

Ангарагийн гадаргууны ГАЙХАЛТАЙ зургууд
Ангараг гараг дэлхийтэй адилхан биш ч гэлээ хамгийн төстэй нь юм. Төстэй гэдгийн учир нь байгалийн ерөнхий төрх байдалтай холбоотой.
2006 оноос хойш Mars Reconnaissance Orbiter сансрын хөлөг өндөр хүчин чадалтай HiRISE камерыг ашиглаж Ангараг гарагийн гадаргууны зургуудыг буулгажээ.
Сайн анзаарвал Ангараг гарагийн гадаргуу яг л мөс, цас, уул нурууд, ой мод, хад асга, элс шороогоор бүрхэгдсэн мэт байгааг та олж харна.
Олон жилийн турш буулгасан зургуудаас хамгийн сонирхолтой, үзэсгэлэнтэйг нь толилуулж байна
Эх сурвалж: BI

Хэвлэл мэдээллийн байгууллагууд (Телевиз, Радио, Social болон Вэб хуудаснууд) манай мэдээллийг аливаа хэлбэрээр бүрэн ба хэсэгчлэн авч ашиглах хориотой ба зөвхөн зөвшилцсөн тохиолдолд эх сурвалжийг (ikon.mn) дурдах замаар ашиглах ёстойг анхаарна уу!
